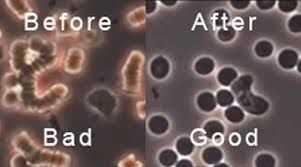

Mi top diez favoritos vida cotidiana hacks!Cuando termines con este instructable, si desea ver más de mis videos o algunos otros tutoriales paso a paso, revisa mi canal de YouTube y página web. Haré lo posible para mantener las cosas frescas e intere
Este instructable explicaré mi teoría del tazón de fuente de Salsa y cómo aplicarlo a tu vida para mejorar tu placer comedor e impresionar a sus amigos!!!! Oh, sí, me refiero a la salsa, la comida, no la danza (aunque puede ser cierto para el baile,
Hola amigos!Es muy molesto tener un buen día por alguna enfermedad.Como todos sufrimos de problemas médicos comunes como dolor de cabeza, mareo por movimiento, frío, dolores etc.. Aquí en este instructable voy a decirle algunos remedios caseros más e
Este remedio casero es lo mejor que he encontrado para ayudar a los dientes, las encías y respiración.Paso 1: Método fácil para mejorar la salud oral Tirando aceite es una técnica simple que deriva de la antigua medicina ayurvédica (India) que se rem
qué frustrante es cuando intenta conseguir algo hecho, sale mal, y es totalmente confundido en cómo resolverlo? Dependiendo de lo que es, esta situación podría acabar siendo muy caro, peligroso, interminable, o izquierda y olvidado sobre. Cosas como
[autopromoción DESVERGONZADA: Si te gusta este tipo de estilo de escritura, no dude en visitar mi blog, en el siglo XXI, www.tristramshandy21st.blogspot.comcerveza con limonada de Tristram. Si no te gusta mi estilo, no visito el blog! No quiero ning
El equipo probablemente no funcionando tan rápido como lo permite. Nuestro PC se llene con todo tipo de archivos, documentos, música, videos, juegos, sino también virus y spyware. Con el tiempo, PC consigue sobrecargado y puede demorar mucho. Esta gu
Esto fue planeado para ser un Instructable sin fotos, pero tuve que realizar sin fotos es difícil de entender, así que añadido algunos así como clips de vídeo.Tengo enormes problemas encontrar enlaces para ver fotos de marcas que no tienen los derech
Este es mi primer ible y solamente mi tercera soldadura proyecto... siempre. Por favor saben que soy * muy * consciente que mis soldaduras deben mejorar. Yo simplemente elegir para mejorar como hacer cosas, en lugar de con un montón de tirar las sold
Actualización 07/03/2015: He encontrado la solución - ver el último paso!Cómo hizo todos empezar te preguntarás, por lo que le permitirá saber ;)Usted podría haber visto mi Instructable para el calentador de inducción Simple y con mi primero sentí la
al pensar en la calidad del aire interior, hornos y acondicionadores de aire central debe venir a la mente. Después de todo, cada pie cúbico de aire en una casa se dibuja finalmente a través de estos sistemas - y se altera por el proceso. El aire es
Empecé a aprender piano hace unos meses por lo que estuve buscando clases de piano para principiantes y canciones fáciles para tocar en el piano.Es el secreto para un aprendizaje exitoso: está motivado porque se pueden jugar canciones de piano fácil
tener un hogar seguro es algo que personas se esfuerzan por lograr, especialmente si tienen objetos de valor y de una familia dentro. Algunas personas sólo compran un sistema de seguridad todo que nunca es una mala idea, puede ir en línea y aprender
esta vez yo no mostrarle nada fancy ni bien obligatorio, pero creeme que será mejorar la vida del enchufe de 6,5 meses a 2 años, créeme, trabajó tan grande, ha tenido este mod desde el muelle ridículamente inteligente y han sobrevivido hasta ahora, (